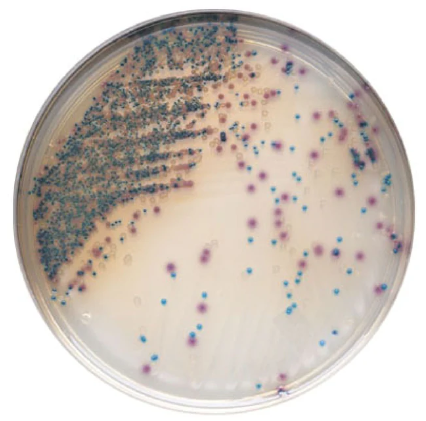
BD 215081 CHROMagar Orientation Plate

BD 215081 CHROMagar Orientation Plate
The BD 215081 CHROMagar Orientation Plate is a high-quality microbiology tool designed for use in clinical laboratories, hospitals, and research institutions. This innovative product provides a convenient and efficient way to orient and organize agar plates, streamlining workflow and reducing errors in microbiological testing. With its unique design and functionality, the BD 215081 CHROMagar Orientation Plate is an essential tool for any laboratory setting where accuracy and efficiency are paramount.
The BD 215081 CHROMagar Orientation Plate is designed to provide a standardized and organized approach to microbiological testing. The plate is divided into quadrants, allowing for easy orientation and identification of samples. This product is intended for use with CHROMagar, a chromogenic medium that provides a simple and reliable way to detect and identify microorganisms.
Key Features
- Convenient and organized design for streamlined workflow
- Divided into quadrants for easy sample identification
- Compatible with CHROMagar chromogenic medium
- Reduces errors in microbiological testing
- Easy to use and integrate into existing laboratory protocols
- High-quality construction for durability and reliability
- Package includes 100 plates for high-volume testing
Product Specifications
The BD 215081 CHROMagar Orientation Plate has the following specifications: * Dimensions: not available * Weight: not available * Materials: not available * Compliance: not available * Compatibility: designed for use with CHROMagar chromogenic mediumIdeal For
The BD 215081 CHROMagar Orientation Plate is ideal for use in: * Clinical laboratories * Hospitals * Research institutions * Microbiology laboratories * Public health laboratories * Industrial laboratoriesShare Product Link:
